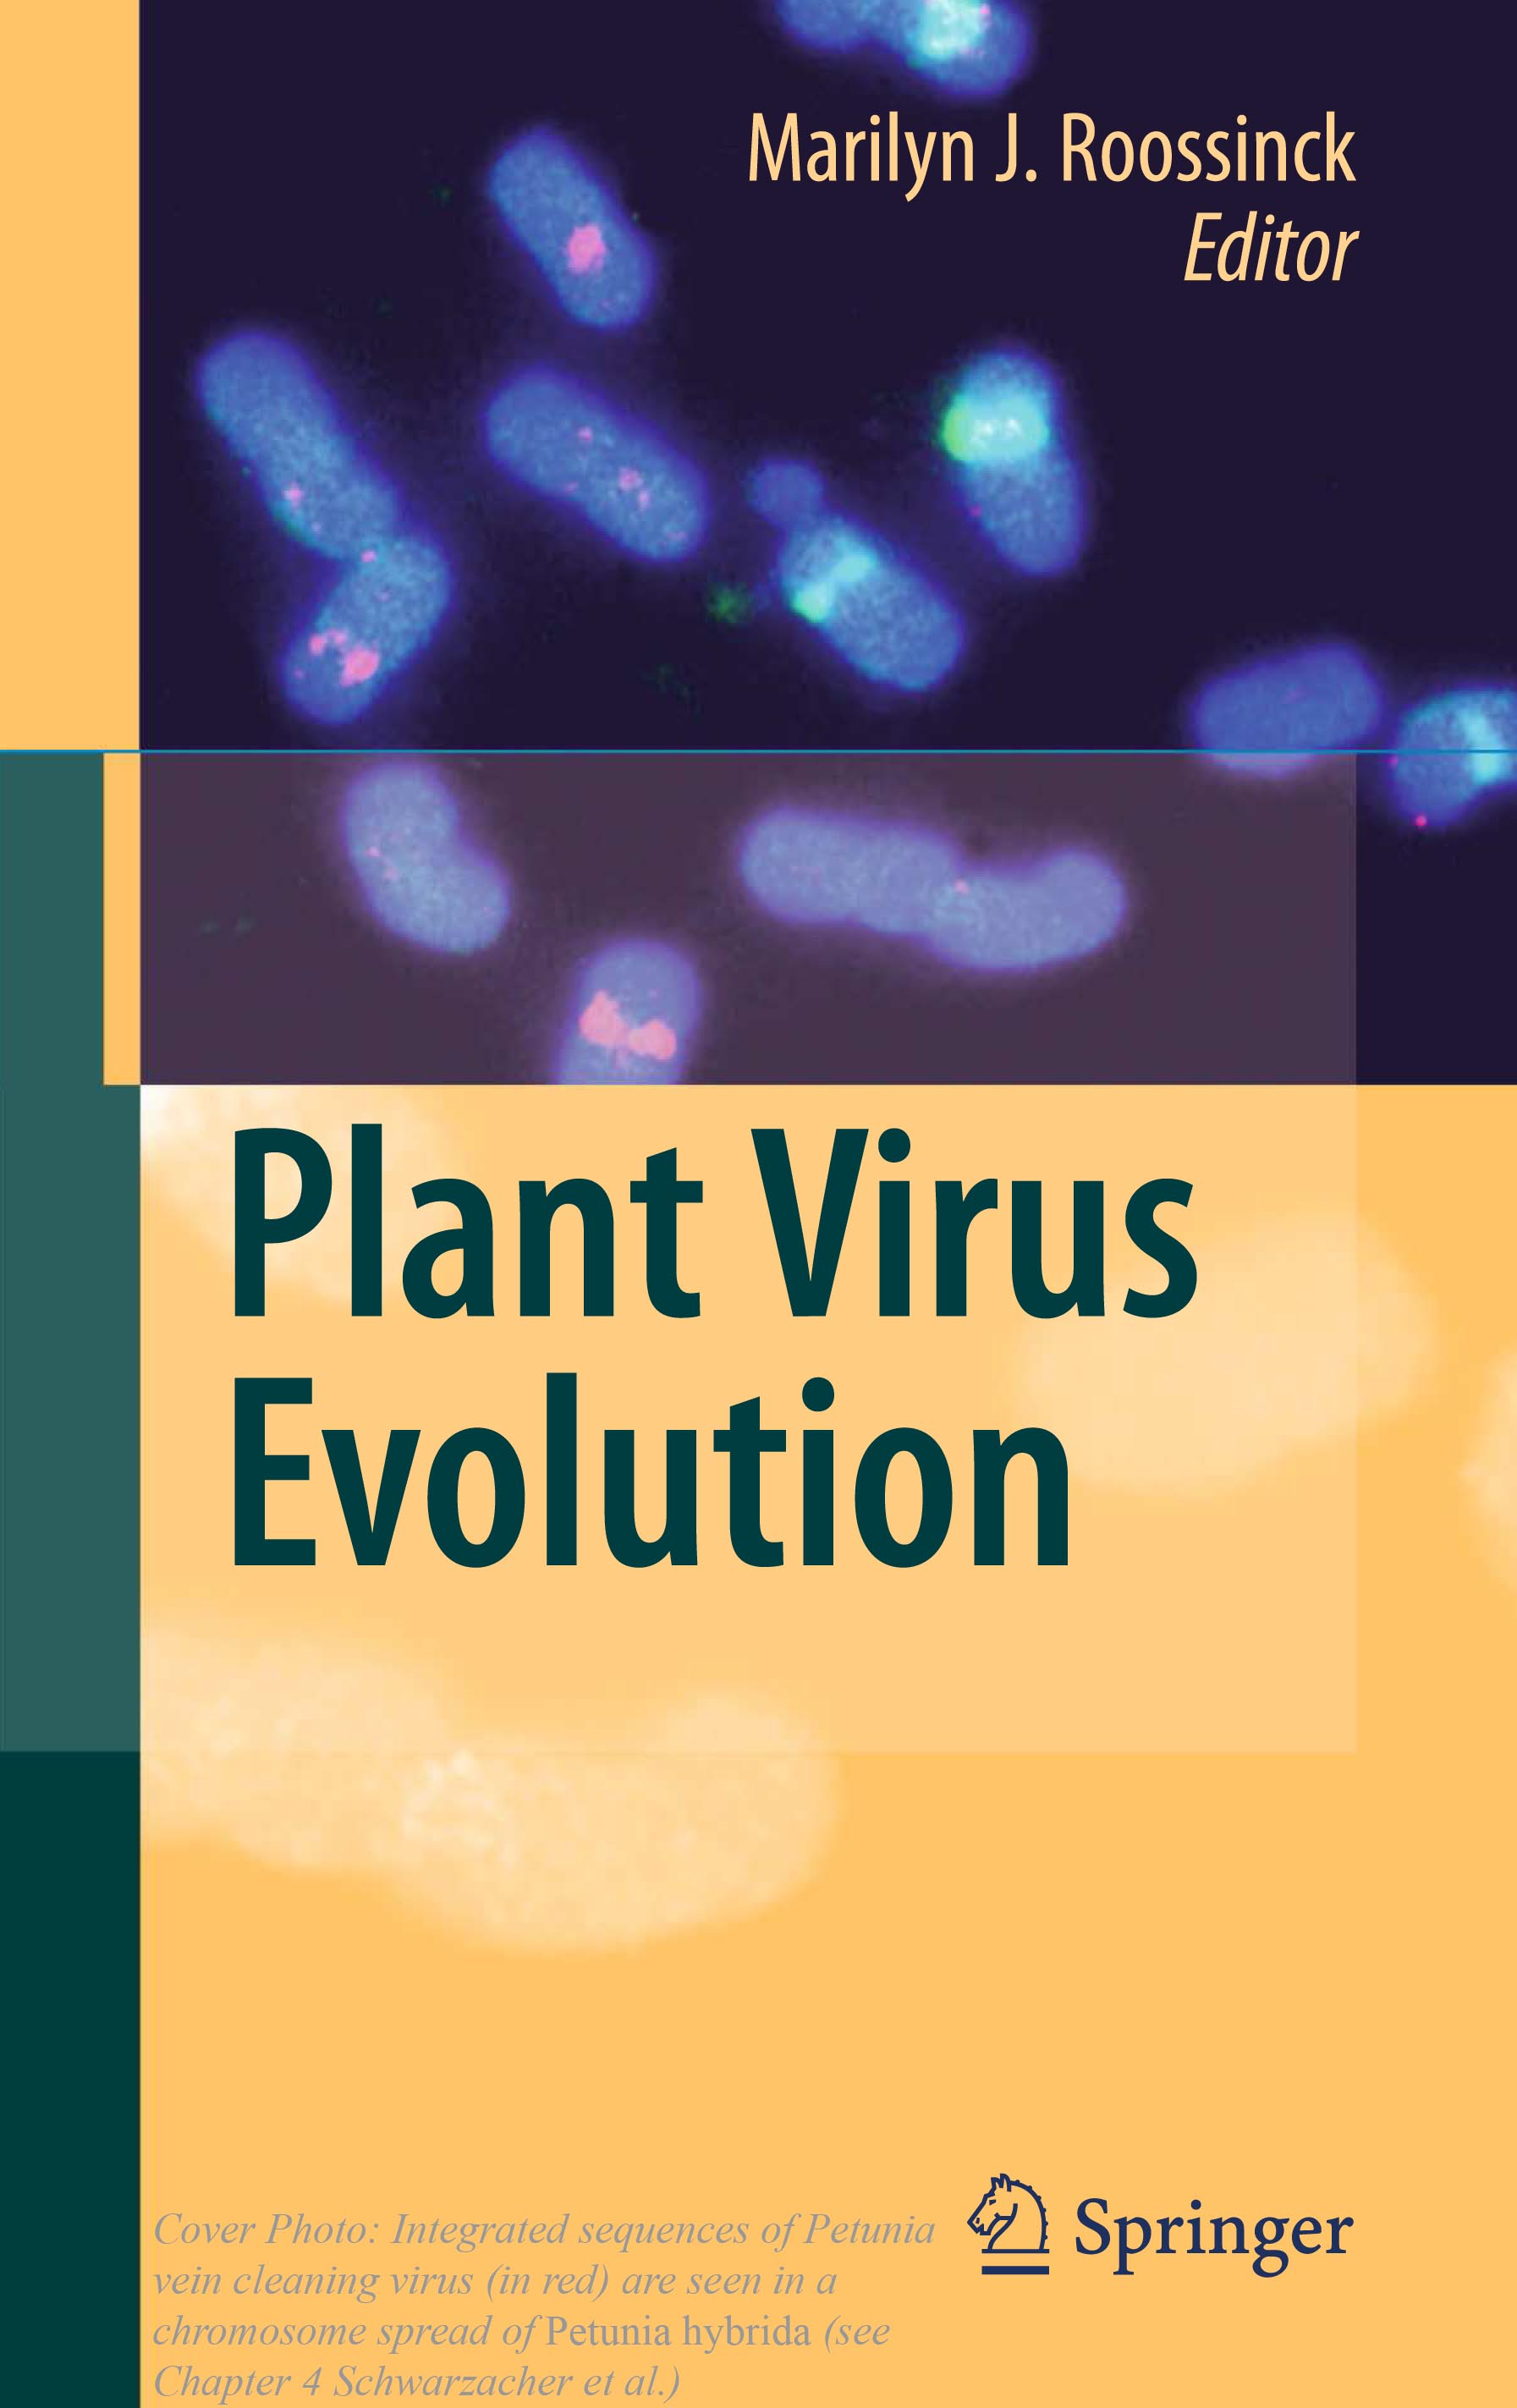

TS. Hohn T, Richert-Pöggeler KR, Staginnus C, Harper G, Schwarzacher T, Teo CH, Teycheney P-Y, Iskra-Caruana M-L, Hull R. 2008. Evolution of Integrated Plant Viruses. Chapter 4 pp 53-81. In: Plant Virus Evolution Ed Roossinck MJ. Springer: Berlin
Link to Publisher homepage about the book with links to downloadable copies of the whole book or the chapter.
(Freely downloadable direct links do not seem to work except via the page above: PRV Pararetrovirus chapter or as the whole book”Plant Virus Evolution” 4Mb.)
This volume has just become free on-line. Despite being 7 years old, it had enough genomic information that the pararetrovirus (EPRV Endogenous Para Retro Virus) chapter is still current in 2015. It also foreshadowed the Journal papers linked via Google Scholar at the bottom of this page.
Plant pararetroviruses replicate their genome via a transcription–reverse transcription cycle like retroviruses, but unlike them their genomes do not obligatorily integrate into the host chromatin. Nevertheless, one can find complete or fragmented pararetrovirus PRV EPRV genomes, as well as those from geminiviruses and even RNA viruses incorporated into the genomes of nearly all plants analysed. Integration events are thought to be rare and even rarer are those that find their way into the germ line. Normally, these integrated viral sequences are incomplete, rearranged and mutated and cannot easily escape as active viruses. However, in some cases apparently more recently acquired and therefore less initiated integrates can escape by direct transcription from tandem insertions or by recombination. This can lead to severe outbreaks in crop and ornamental plants. In anticipation of such events, methods have been developed for the detection and characterization of integrated virus sequences in plant genomes.
See more recent journal articles on PRVs EPRVs relating to the work overviewed in this chapter
[HTML] Endogenous pararetroviral sequences in tomato (Solanum lycopersicum) and related species
Fluorescent in situ hybridization to detect transgene integration into plant genomes
Impact of Retroelements in Shaping the Petunia Genome
Potential Impact and Risks of Endogenous Plant Viruses in Cultivation of Petunia Illustrated by Endogenous Petunia Vein Clearing (Pararetro-) Virus (ePVCV)
.
.
adverts below not associated.
